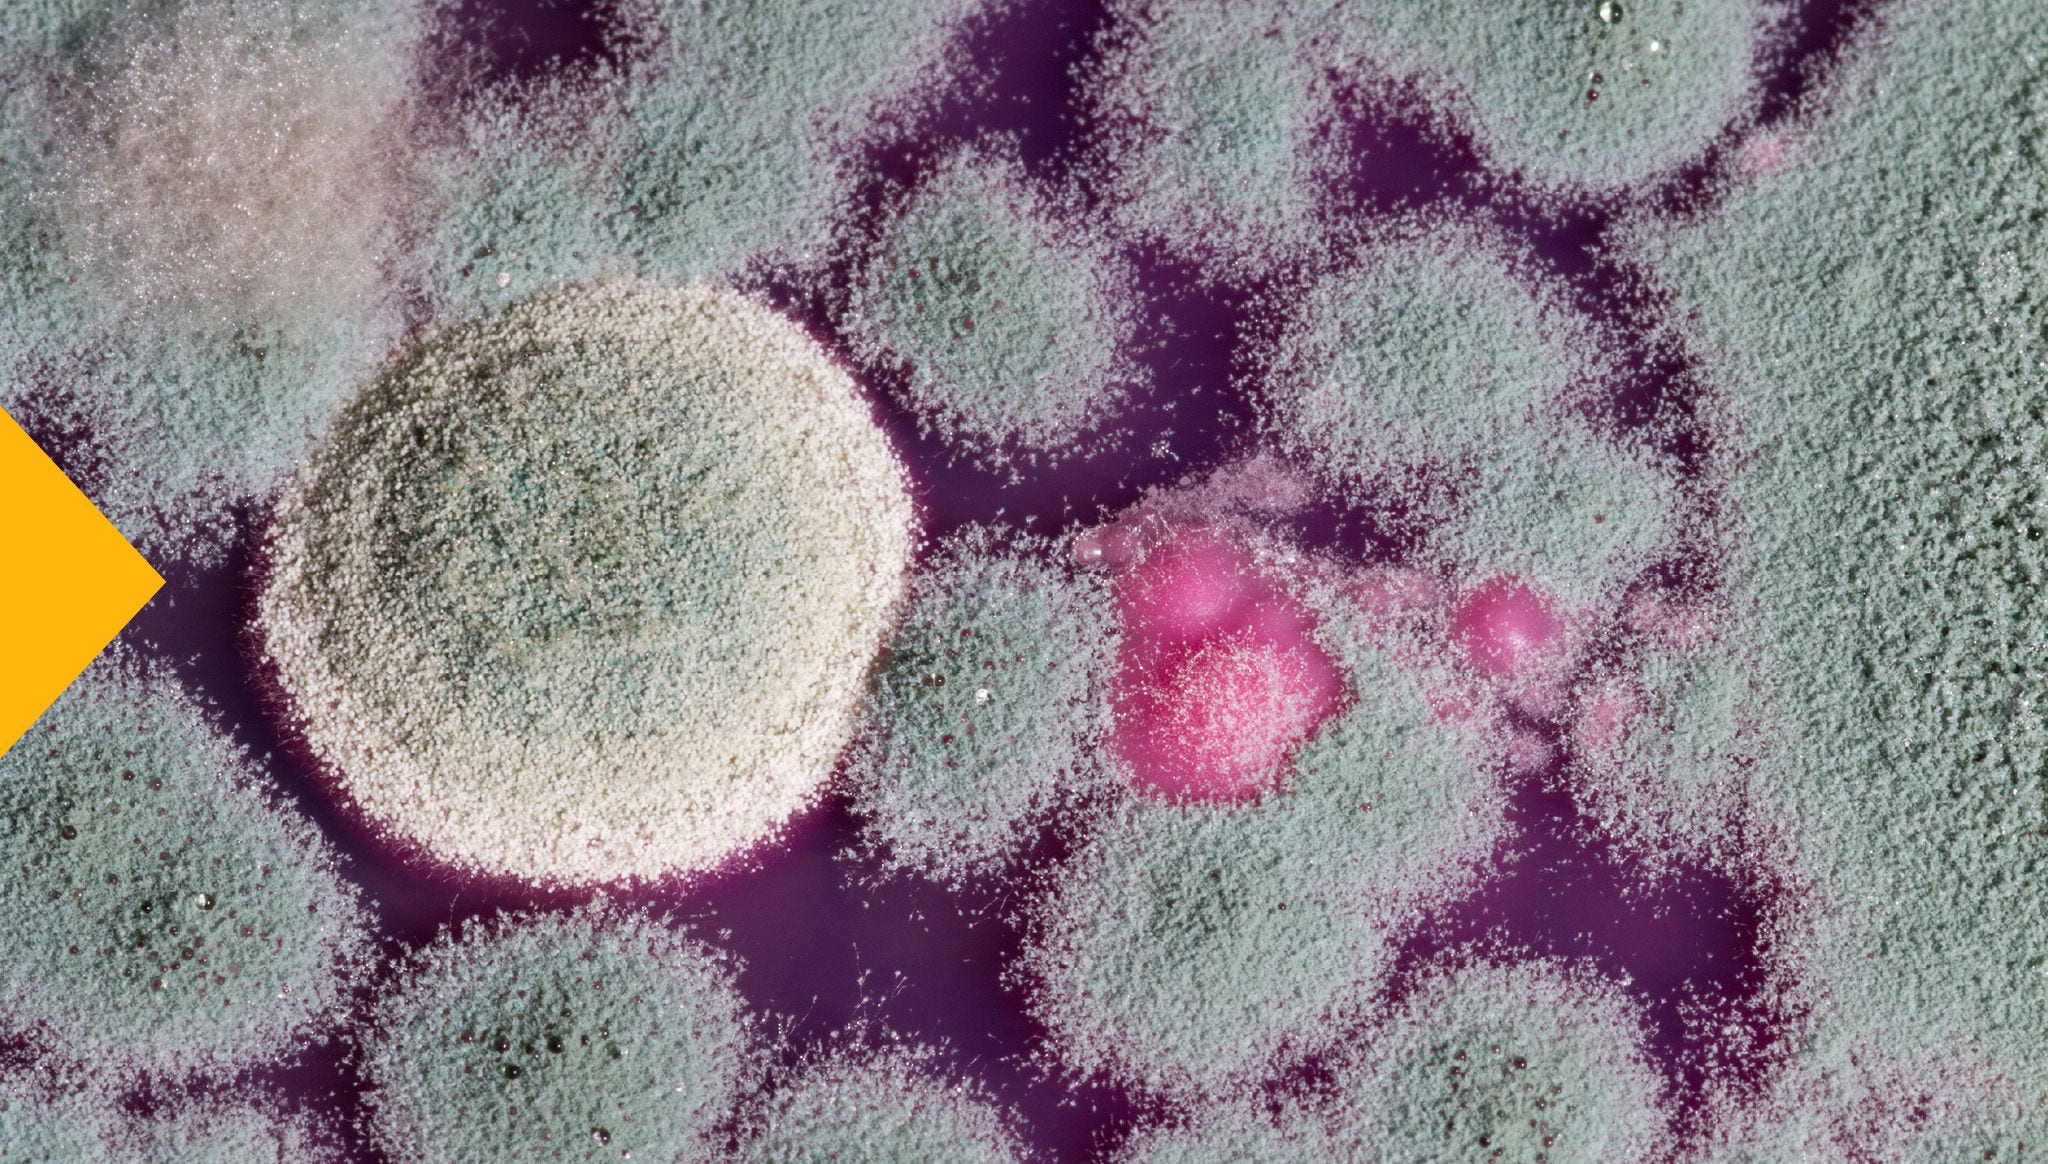

MICROBAN – ADDITIONAL PROTECTION IN THE VEHICLE'S CABIN

Additional passenger protection, thanks to the innovative MICROBAN technology!
EVERY CABIN FILTERWIX FILTERS HASMICROBAN TECHNOLOGY |  ACTIVATED CARBON FILTER |  STANDARD FILTER |
|---|---|---|

|
|
|

|
|
|

|
|